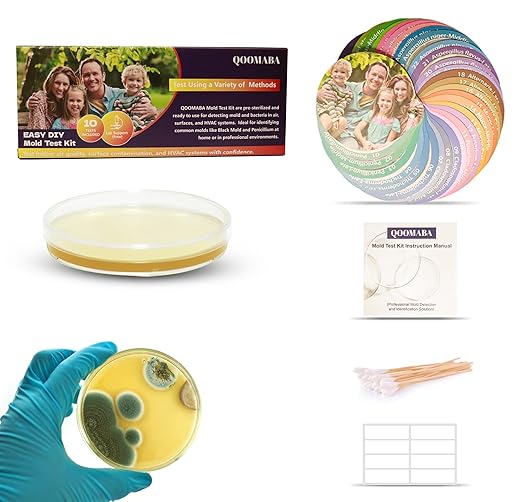
Mold Test Kit for Home Air Quality 10PCS - Mold Toxicity Test for HVAC, at Home Mold Test Kit, Mold Detector for Home Air Quality - Black Mold Testing Kit Air with Guide and Lab Support

QOOMABA
Mold Test Kit for Home Air Quality 10PCS - Mold Toxicity Test for HVAC, at Home Mold Test Kit, Mold Detector for Home Air Quality - Black Mold Testing Kit Air with Guide and Lab Support
Mold Test Kit for Home Air Quality 10PCS - Mold Toxicity Test for HVAC, at Home Mold Test Kit, Mold Detector for Home Air Quality - Black Mold Testing Kit Air with Guide and Lab Support
Couldn't load pickup availability
About This
- Visual Mold Growth Comparison Cards for Clear Detection Our QOOMABA Mold Test Kit includes unique visual comparison cards showing mold growth stages (early, middle, and late). These cards help you identify and compare mold types easily. With vivid, high-quality images and distinctive colors, they ensure accurate mold detection for black mold and indoor allergen testing, making it perfect for air mold test kits and air quality tests in your home.
- Comprehensive Testing Kit for Home Mold Detection The QOOMABA Mold Test Kit includes everything needed for at-home mold testing kits: testing plates, swabs, adhesive labels, comparison cards, and a manual. Use the plates to test areas like furniture, showers, HVAC systems, and walls for mold types. This mold test kit for home air quality is simple, effective, and ensures accurate results for mold toxicity tests and exposure detection.
- Flexible Mold Testing Options for Every Home QOOMABA offers mold test kits in 2, 4, 5, 10, 15, and 30 packs, ideal for homes of all sizes. Test HVAC systems, walls, and furniture for black mold and air quality issues. With precise results, QOOMABA is the best home mold testing kit for ensuring safe, mold-free environments. Whether for air mold testers or testing your home air quality, you can trust the results for a healthier home.
- Free Laboratory Identification and Expert Support Send photos of mold growth on your plates to our support team for free expert analysis. We offer professional laboratory data for precise mold identification, helping you take the best action for mold removal and prevention. This free service ensures your home stays mold-free, whether you’re using a mold air test kit or conducting a mold exposure test for peace of mind.
- Safe, Non-Toxic, and Easy-to-Use Mold Detection Kit The QOOMABA Mold Test Kit is designed for safe, contamination-free testing at home. It includes swabs and sealed plates, ideal for high-risk areas like bathrooms, kitchens, and basements. Whether testing for black mold or using an air mold detector, this DIY mold test kit ensures accurate results. With clear instructions, it’s perfect for first-time users to confidently test and detect mold in their homes.